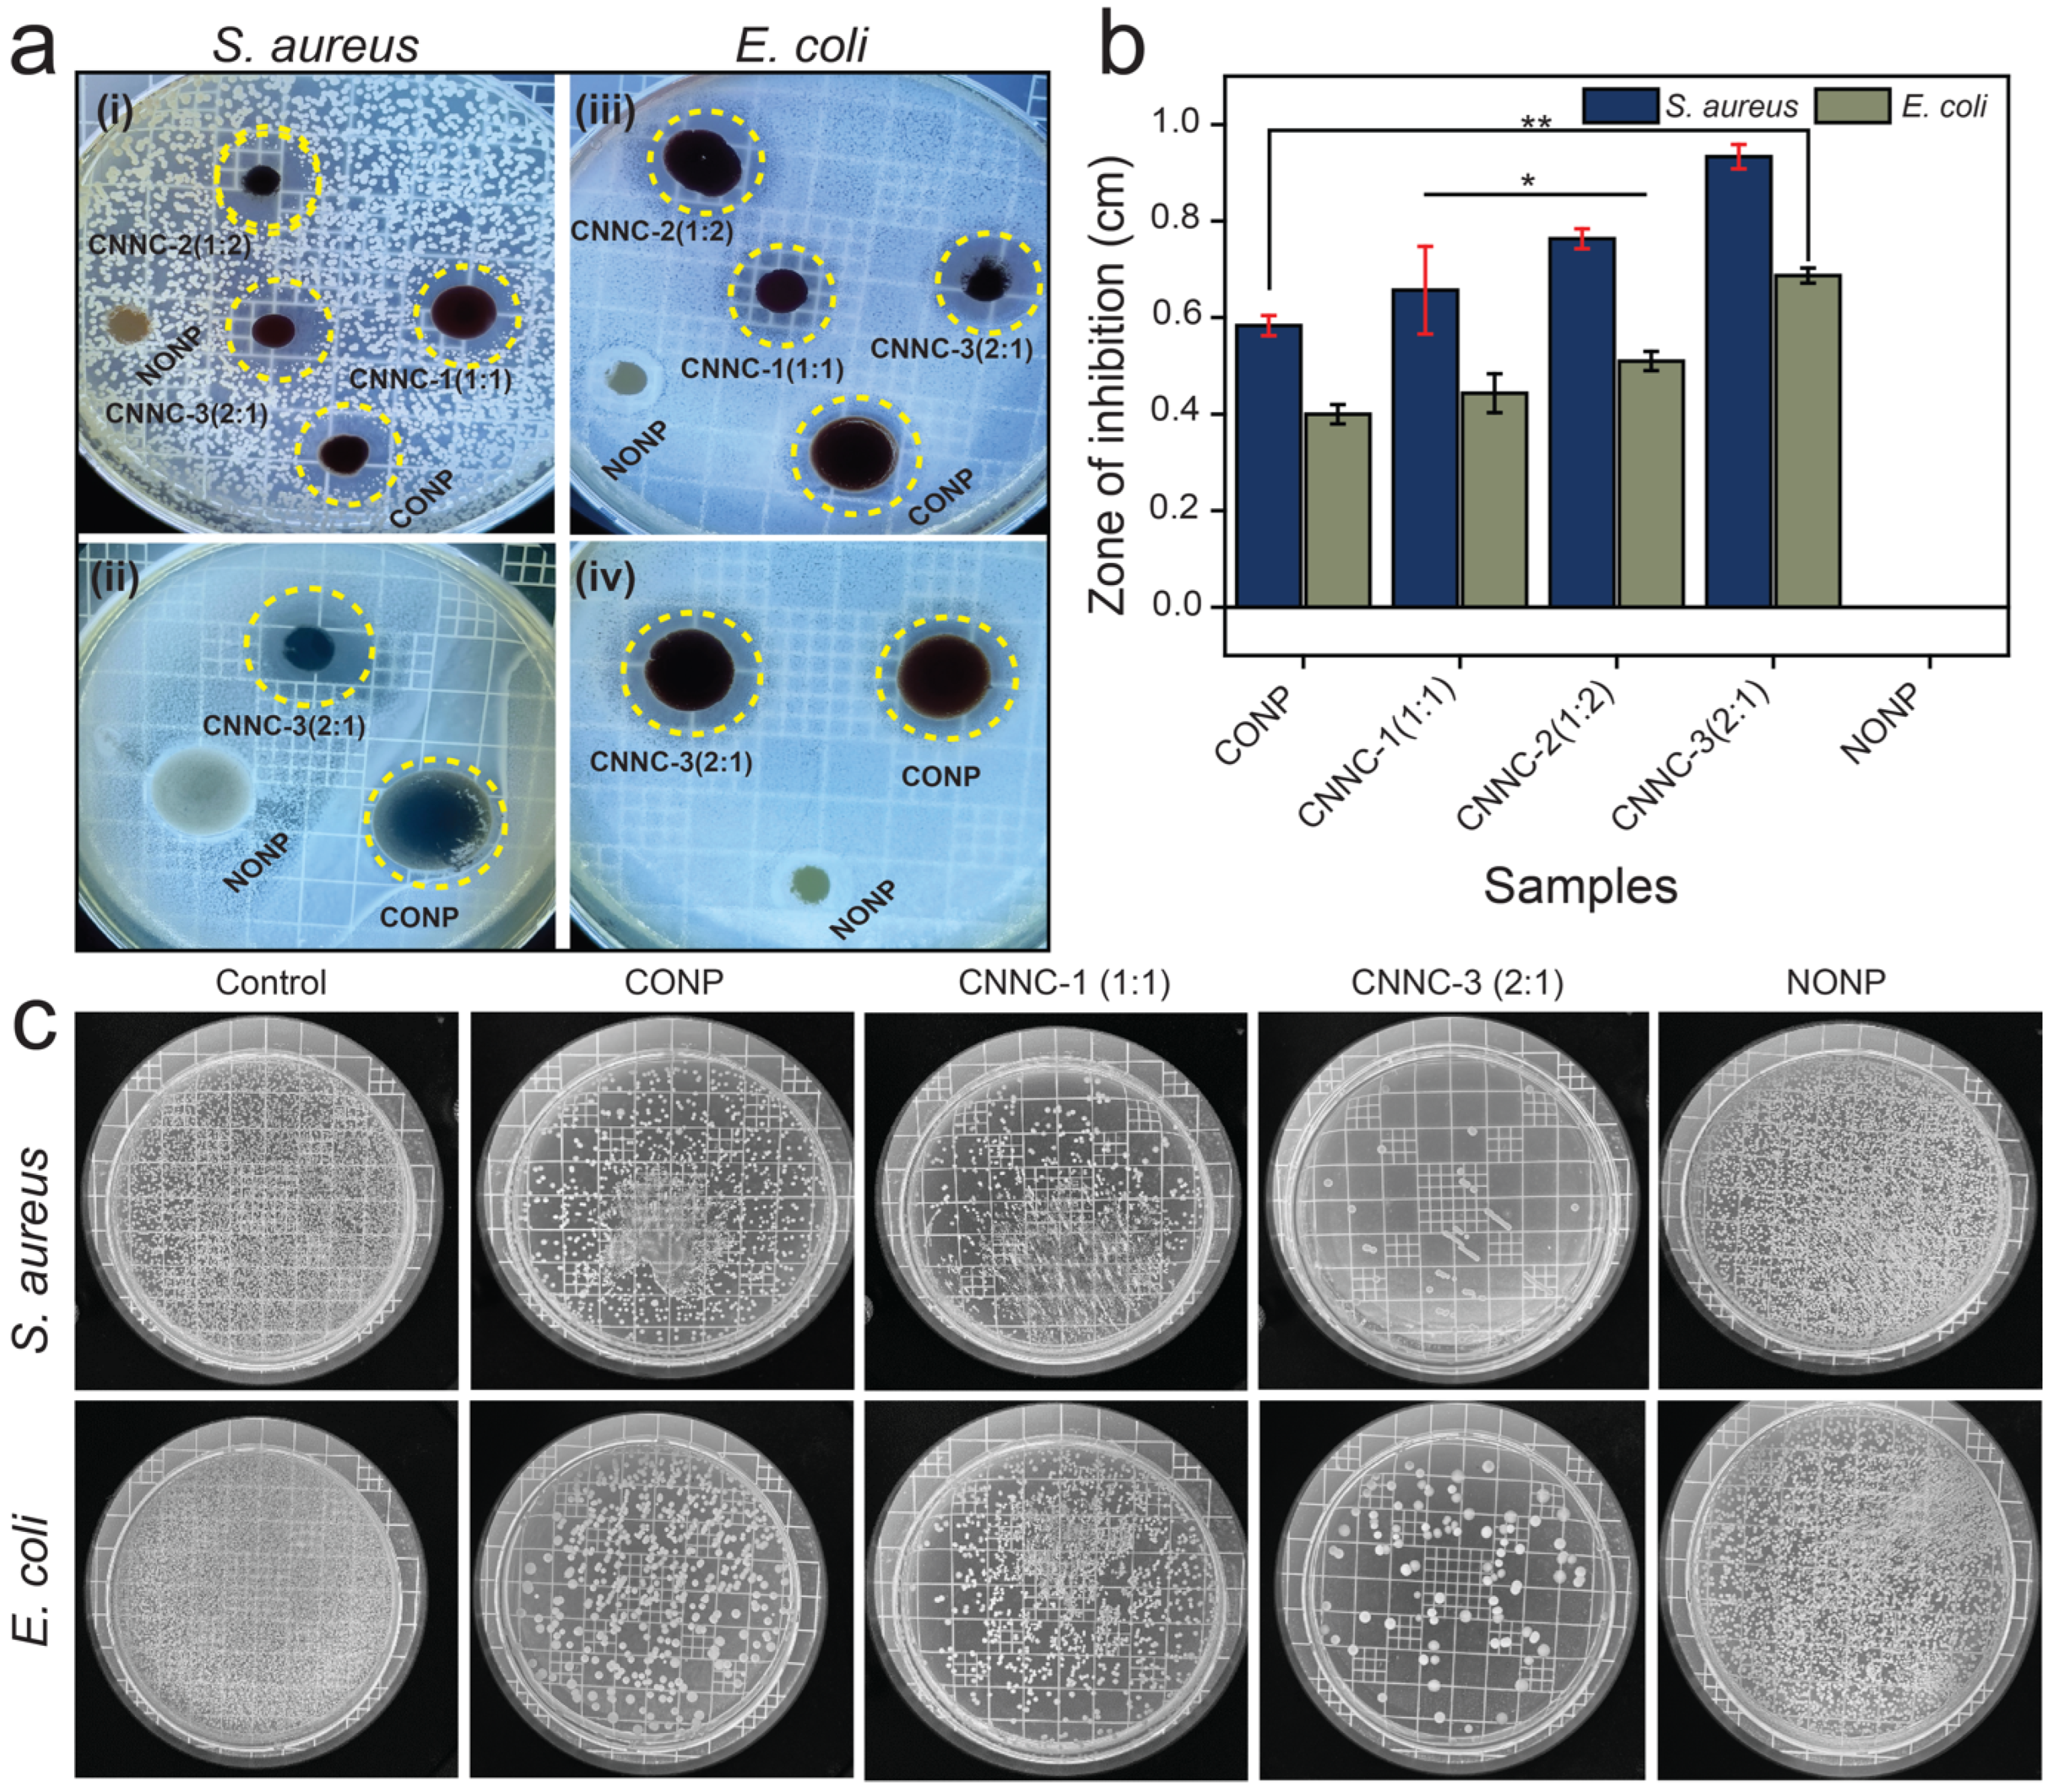
Molecules 30 02561 g009

Visible-Light-Driven Co3O4/Nb2O5 Heterojunction Nanocomposites for Efficient Photocatalytic and Antimicrobial Performance in Wastewater Treatment
Abstract
1. Introduction
2. Results and Discussion
2.1. Surface Morphology and Elemental Analysis
2.2. Structural Characterization
2.3. Optical Characterization and Charge-Transfer Efficiency
2.4. Photocatalytic Degradation Performance
2.5. Bactericidal Activity
2.6. Effect of Catalyst Dose, Pollutant Dose, Reusability, and Stability of Photocatalyst
2.7. Effects of pHpzc and pH on Photocatalytic Decomposition
2.8. Trapping Experiments
2.9. Liquid Chromatography–Mass Spectrometry Analysis
2.10. Proposed Photocatalytic Mechanism
3. Experimental
3.1. Chemicals
3.2. Synthesis of CNNC
3.3. Synthesis of CONP and NONP
3.4. Characterization Techniques
3.5. Antibacterial Activity
3.6. Photocatalytic Experiments
3.7. Reusability Assessment
4. Conclusions
Supplementary Materials
Author Contributions
Funding
Institutional Review Board Statement
Informed Consent Statement
Data Availability Statement
Conflicts of Interest
References
- Nicoloff, H.; Hjort, K.; Levin, B.R.; Andersson, D.I. The high prevalence of antibiotic heteroresistance in pathogenic bacteria is mainly caused by gene amplification. Nat. Microbiol. 2019, 4, 504–514. [Google Scholar] [CrossRef]
- Liu, H.; Ma, S.; Shao, L.; Liu, H.; Gao, Q.; Li, B.; Fu, H.; Fu, S.; Ye, H.; Zhao, F.; et al. Defective engineering in graphitic carbon nitride nanosheet for efficient photocatalytic pathogenic bacteria disinfection. Appl. Catal. B 2020, 261, 118201. [Google Scholar] [CrossRef]
- Chakravarty, S.; Massé, E. RNA-dependent regulation of virulence in pathogenic bacteria. Front. Cell. Infect. Microbiol. 2019, 9, 337. [Google Scholar] [CrossRef] [PubMed]
- Karim, M.N.; Singh, M.; Weerathunge, P.; Bian, P.; Zheng, R.; Dekiwadia, C.; Ahmed, T.; Walia, S.; Della Gaspera, E.; Singh, S.; et al. Visible-light-triggered reactive-oxygen-species-mediated antibacterial activity of peroxidase-mimic CuO nanorods. ACS Appl. Nano Mater. 2018, 1, 1694–1704. [Google Scholar] [CrossRef]
- Makvandi, P.; Wang, C.y.; Zare, E.N.; Borzacchiello, A.; Niu, L.n.; Tay, F.R. Metal-based nanomaterials in biomedical applications: Antimicrobial activity and cytotoxicity Aspects. Adv. Funct. Mater. 2020, 30, 1910021. [Google Scholar] [CrossRef]
- Gogate, P.R.; Pandit, A.B. A review of imperative technologies for wastewater treatment I: Oxidation technologies at ambient conditions. Adv. Environ. Res. 2004, 8, 501–551. [Google Scholar] [CrossRef]
- Low, J.; Yu, J.; Ho, W. Graphene-based photocatalysts for CO2 reduction to solar fuel. J. Phys. Chem. Lett. 2015, 6, 4244–4251. [Google Scholar] [CrossRef]
- Shrestha, S.; Sapkota, K.P.; Lee, I.; Islam, M.A.; Pandey, A.; Gyawali, N.; Akter, J.; Mohan, H.; Shin, T.; Jeong, S.; et al. Carbon-based ternary nanocomposite: Bullet type ZnO-SWCNT-CuO for substantial solar-driven photocatalytic decomposition of aqueous organic contaminants. Molecules 2022, 27, 8812. [Google Scholar] [CrossRef]
- Khodabandeloo, F.; Shahsavarifar, S.; Nayebi, B.; Niavol, K.P.; Nayebi, B.; Varma, R.S.; Cha, J.H.; Jang, H.W.; Kim, D.; Shokouhimehr, M. Applications of nanostructured semiconductor photocatalysts for the decontamination of assorted pollutants from wastewater. Inorg. Chem. Commun. 2023, 157, 111357. [Google Scholar] [CrossRef]
- Jabbar, Z.H.; Esmail Ebrahim, S. Recent advances in nano-semiconductors photocatalysis for degrading organic contaminants and microbial disinfection in wastewater: A comprehensive review. Environ. Nanotechnol. Monit. Manag. 2022, 17, 100666. [Google Scholar] [CrossRef]
- Li, X.; Zhu, J.; Li, H. Comparative study on the mechanism in photocatalytic degradation of different-type organic dyes on SnS2 and CdS. Appl. Catal. B 2012, 123–124, 174–181. [Google Scholar] [CrossRef]
- Mandal, S.; Adhikari, S.; Pu, S.; Wang, X.; Kim, D.H.; Patel, R.K. Interactive Fe2O3/porous SiO2 nanospheres for photocatalytic degradation of organic pollutants: Kinetic and mechanistic approach. Chemosphere 2019, 234, 596–607. [Google Scholar] [CrossRef]
- Gyawali, N.; Kandel, R.; Lee, I.; Shrestha, S.; Pandey, A.; Akter, J.; Hahn, J.R. Silver decoration of Cr2O3 nanoparticles: Facile preparation of Cr2O3 nanoparticles and Ag–Cr2O3 nanocomposites and characterization of their antibacterial activity and ability to photocatalytically degrade organic wastes under visible light. J. Photochem. Photobiol. A 2024, 447, 115251. [Google Scholar] [CrossRef]
- Zhang, Q.-Q.; Ying, G.-G.; Pan, C.-G.; Liu, Y.-S.; Zhao, J.-L. Comprehensive evaluation of antibiotics emission and fate in the river basins of china: Source analysis, multimedia modeling, and linkage to bacterial resistance. Environ. Sci. Technol. 2015, 49, 6772–6782. [Google Scholar] [CrossRef]
- Shrestha, S.; Amatya, S.P. Biosynthesis of manganese nanoparticles (MnNPs) from brassica oleraceae (cabbage leaves) and its antibacterial activity. Asian J. Chem. Sci. 2021, 9, 1–11. [Google Scholar] [CrossRef]
- Crini, G.; Lichtfouse, E. Advantages and disadvantages of techniques used for wastewater treatment. Environ. Chem. Lett. 2019, 17, 145–155. [Google Scholar] [CrossRef]
- Fujishima, A.; Honda, K. Electrochemical photolysis of water at a semiconductor electrode. Nature 1972, 238, 37–38. [Google Scholar] [CrossRef]
- Raj Kumar, R.; Ramesh, R. Synthesis, molecular structure and electrochemical properties of nickel(ii) benzhydrazone complexes: Influence of ligand substitution on DNA/protein interaction, antioxidant activity and cytotoxicity. RSC Adv. 2015, 5, 101932–101948. [Google Scholar] [CrossRef]
- Gyawali, N.; Lee, I.; Shrestha, S.; Acharya, S.; Zahid, A.; Kim, K.; Sapkota, K.P.; Hahn, J.R. MOF-derived in situ confinement of copper/copper oxide nanoparticles inside a carbon tube: A facile morphologically controlled synthesis strategy for superior visible-light-driven photocatalytic efficiency. Ind. Eng. Chem. Res. 2025, 64, 5212–5227. [Google Scholar] [CrossRef]
- Low, J.; Yu, J.; Jaroniec, M.; Wageh, S.; Al-Ghamdi, A.A. Heterojunction photocatalysts. Adv. Mater. 2017, 29, 1601694. [Google Scholar] [CrossRef]
- Wang, S.; Yang, X.; Zhang, X.; Ding, X.; Yang, Z.; Dai, K.; Chen, H. A plate-on-plate sandwiched Z-scheme heterojunction photocatalyst: BiOBr-Bi2MoO6 with enhanced photocatalytic performance. Appl. Surf. Sci. 2017, 391, 194–201. [Google Scholar] [CrossRef]
- Joshi, B.; Regmi, C.; Dhakal, D.; Gyawali, G.; Lee, S.W. Efficient inactivation of staphylococcus aureus by silver and copper loaded photocatalytic titanate nanotubes. Prog. Nat. Sci. Mater. Int. 2018, 28, 15–23. [Google Scholar] [CrossRef]
- Hao, Q.; Mo, Z.; Chen, Z.; She, X.; Xu, Y.; Song, Y.; Ji, H.; Wu, X.; Yuan, S.; Xu, H.; et al. 0D/2D Fe2O3 quantum dots/g-C3N4 for enhanced visible-light-driven photocatalysis. Colloids Surf. A 2018, 541, 188–194. [Google Scholar] [CrossRef]
- Luo, J.; Zhang, S.; Sun, M.; Yang, L.; Luo, S.; Crittenden, J.C. A critical review on energy conversion and environmental remediation of photocatalysts with remodeling crystal lattice, surface, and interface. ACS Nano 2019, 13, 9811–9840. [Google Scholar] [CrossRef]
- Li, T.; Nam, G.; Liu, K.; Wang, J.-H.; Zhao, B.; Ding, Y.; Soule, L.; Avdeev, M.; Luo, Z.; Zhang, W.; et al. A niobium oxide with a shear structure and planar defects for high-power lithium ion batteries. Energy Environ. Sci. 2022, 15, 254–264. [Google Scholar] [CrossRef]
- Dsouki, N.A.; de Lima, M.P.; Corazzini, R.; Gascon, T.M.; Azzalis, L.A.; Junqueira, V.B.; Feder, D.; Fonseca, F.L. Cytotoxic, hematologic and histologic effects of niobium pentoxide in Swiss mice. J. Mater. Sci Mater. Med. 2014, 25, 1301–1305. [Google Scholar] [CrossRef]
- Hong, Y.; Li, C.; Zhang, G.; Meng, Y.; Yin, B.; Zhao, Y.; Shi, W. Efficient and stable Nb2O5 modified g-C3N4 photocatalyst for removal of antibiotic pollutant. Chem. Eng. J. 2016, 299, 74–84. [Google Scholar] [CrossRef]
- Jones, B.M.F.; Mamba, G.; Maruthamani, D.; Muthuraj, V. Honeycomb Nb2O5/RGO wrapped on MoO3 nanorods for visible light-driven degradation of sulfasalazine and ciprofloxacin in water. Colloids Surf. A 2022, 653, 129836. [Google Scholar] [CrossRef]
- Su, K.; Liu, H.; Gao, Z.; Fornasiero, P.; Wang, F. Nb2O5-based photocatalysts. Adv. Sci. 2021, 8, 2003156. [Google Scholar] [CrossRef]
- Aimaiti, G.; Ma, Y.; Shi, Y.; Wang, X.; Wang, S.; Wang, Z.; Li, Y.; Li, J.; Qi, X.; Chen, X. Nb2O5/red phosphorus S-scheme heterojunction photocatalyst for removal of organic contaminant and Cr(VI): Electrochemical performance and mechanism. Mater. Sci. Semicond. Process. 2023, 160, 107421. [Google Scholar] [CrossRef]
- Nogueira, A.E.; Lopes, O.F.; Neto, A.B.S.; Ribeiro, C. Enhanced Cr(VI) photoreduction in aqueous solution using Nb2O5/CuO heterostructures under UV and visible irradiation. Chem. Eng. J. 2017, 312, 220–227. [Google Scholar] [CrossRef]
- Wu, J.; Li, J.; Liu, J.; Bai, J.; Yang, L. A novel Nb2O5/Bi2WO6 heterojunction photocatalytic oxidative desulfurization catalyst with high visible light-induced photocatalytic activity. RSC Adv. 2017, 7, 51046–51054. [Google Scholar] [CrossRef]
- Gao, B.; Fu, J.; Huo, K.; Zhang, W.; Xie, Y.; Chu, P.K. Quasi-aligned Ag–Nb2O5 nanobelt arrays with enhanced photocatalytic and antibacterial activities. J. Am. Ceram. Soc. 2011, 94, 2330–2338. [Google Scholar] [CrossRef]
- Ren, X.; Shi, J.; Duan, R.; Di, J.; Xue, C.; Luo, X.; Liu, Q.; Xia, M.; Lin, B.; Tang, W. Construction of high-efficiency CoS@Nb2O5 heterojunctions accelerating charge transfer for boosting photocatalytic hydrogen evolution. Chin. Chem. Lett. 2022, 33, 4700–4704. [Google Scholar] [CrossRef]
- Tian, M.; Su, F.; Wang, Z.; Xiao, Y.; Zhang, Y.; Gao, Y.; Zhao, Q.; Jin, X.; Li, X.; Xie, H. Constructing a stable CdS/Nb2O5 Z-scheme heterojunction for efficient photocatalytic conversion of CO2. Mol. Catal. 2025, 576, 114930. [Google Scholar] [CrossRef]
- Wang, Y.; Kong, X.; Jiang, M.; Zhang, F.; Lei, X. A Z-scheme ZnIn2S4/Nb2O5 nanocomposite: Constructed and used as an efficient bifunctional photocatalyst for H2 evolution and oxidation of 5-hydroxymethylfurfural. Inor. Chem. Front. 2020, 7, 437–446. [Google Scholar] [CrossRef]
- Souza, L.V.S.; Pavanello, L.; Picolo, M.Z.D.; Kury, M.; Matos, I.; Cogo-Muller, K.; Esteban Florez, F.L.; Cavalli, V. Mechanical and antibacterial properties of an experimental flowable composite containing Nb2O5 and NF_TiO2 nanoparticles. J. Mech. Behav. Biomed. Mater. 2023, 143, 105919. [Google Scholar] [CrossRef]
- Madhavi, B.; Siva Sesha Reddy, A.; Syam Prasad, P.; Prasad, A.; Pavani Koteswari Devi, P.; Ravi Kumar, V.; Veeraiah, N. The impact of Nb2O5 on in-vitro bioactivity and antibacterial activity of CaF2–CaO–B2O3–P2O5–SrO glass system. Ceram. Int. 2021, 47, 28328–28337. [Google Scholar] [CrossRef]
- Safavi, M.S.; Khalil-Allafi, J.; Restivo, E.; Ghalandarzadeh, A.; Hosseini, M.; Dacarro, G.; Malavasi, L.; Milella, A.; Listorti, A.; Visai, L. Enhanced in vitro immersion behavior and antibacterial activity of NiTi orthopedic biomaterial by HAp-Nb2O5 composite deposits. Sci. Rep. 2023, 13, 16045. [Google Scholar] [CrossRef]
- Chauhan, A.; Kumar, R.; Devi, S.; Sonu; Raizada, P.; Singh, P.; Ponnusamy, V.K.; Sudhaik, A.; Mishra, A.K.; Selvasembian, R. Recent advances on Co3O4-based nanostructure photocatalysis: Structure, synthesis, modification strategies, and applications. Surf. Interfaces 2024, 54, 105152. [Google Scholar] [CrossRef]
- Kumar, S.; Kaur, G.; Rawat, M.; Tsang, Y.F.; Lin, K.-Y.; Kim, K.-H. Potential of piper betle@Co3O4 nanoparticles as high-performance photocatalysts for the removal of industrial dyes. J. Clean. Prod. 2022, 361, 132242. [Google Scholar] [CrossRef]
- Wang, Y.; Zhu, C.; Zuo, G.; Guo, Y.; Xiao, W.; Dai, Y.; Kong, J.; Xu, X.; Zhou, Y.; Xie, A.; et al. 0D/2D Co3O4/TiO2 Z-Scheme heterojunction for boosted photocatalytic degradation and mechanism investigation. Appl. Catal. B 2020, 278, 119298. [Google Scholar] [CrossRef]
- Subagyo, R.; Yudhowijoyo, A.; Sholeha, N.A.; Hutagalung, S.S.; Prasetyoko, D.; Birowosuto, M.D.; Arramel, A.; Jiang, J.; Kusumawati, Y. Recent advances of modification effect in Co3O4-based catalyst towards highly efficient photocatalysis. J. Colloid Interface Sci. 2023, 650, 1550–1590. [Google Scholar] [CrossRef] [PubMed]
- Tran, V.A.; Phung, T.K.; Le, V.T.; Vo, T.K.; Nguyen, T.T.; Nguyen, T.A.N.; Viet, D.; Hieu, V.Q.; Vo, T.-T.T. Solar-light-driven photocatalytic degradation of methyl orange dye over Co3O4-ZnO nanoparticles. Mater. Lett. 2021, 284, 128902. [Google Scholar] [CrossRef]
- Raja, V.; Puvaneswaran, S.K.; Swaminathan, K. Unique and hierarchically structured novel Co3O4/NiO nanosponges with superior photocatalytic activity against organic contaminants. Front. Mater. Sci. 2017, 11, 375–384. [Google Scholar] [CrossRef]
- Shen, C.-H.; Wen, X.-J.; Fei, Z.-H.; Liu, Z.-T.; Mu, Q.-M. Visible-light-driven activation of peroxymonosulfate for accelerating ciprofloxacin degradation using CeO2/Co3O4 p-n heterojunction photocatalysts. Chem. Eng. J. 2020, 391, 123612. [Google Scholar] [CrossRef]
- Malefane, M.E.; Feleni, U.; Kuvarega, A.T. Cobalt (II/III) oxide and tungsten (VI) oxide p-n heterojunction photocatalyst for photodegradation of diclofenac sodium under visible light. J. Environ. Chem. Eng. 2020, 8, 103560. [Google Scholar] [CrossRef]
- Yousefi, S.R.; Alshamsi, H.A.; Amiri, O.; Salavati-Niasari, M. Synthesis, characterization and application of Co/Co3O4 nanocomposites as an effective photocatalyst for discoloration of organic dye contaminants in wastewater and antibacterial properties. J. Mol. Liq. 2021, 337, 116405. [Google Scholar] [CrossRef]
- Wang, X.; Shao, Y.; Yao, C.; Huang, L.; Song, W.; Yang, X.; Zhang, Z. 2D/2D Co3O4/BiOCl nanocomposite with enhanced antibacterial activity under full spectrum: Synergism of mesoporous structure, photothermal effect and photocatalytic reactive oxygen species. J. Colloid Interface Sci. 2025, 678, 30–41. [Google Scholar] [CrossRef]
- Liyanaarachchi, H.; Thambiliyagodage, C.; Jayanetti, M.; Ekanayake, G.; Wijayawardana, S.; Samarakoon, U. The photocatalytic and antibacterial activity of graphene oxide coupled CoOx /MnOx nanocomposites. Environ. Technol. Innov. 2025, 37, 103984. [Google Scholar] [CrossRef]
- Guo, M.; Xu, K.; Qu, Y.; Zeng, F.; Yuan, C. Porous Co3O4/CoS2 nanosheet-assembled hierarchical microspheres as superior electrocatalyst towards oxygen evolution reaction. Electrochim. Acta 2018, 268, 10–19. [Google Scholar] [CrossRef]
- Li, Z.; Yu, X.-Y.; Paik, U. Facile preparation of porous Co3O4 nanosheets for high-performance lithium ion batteries and oxygen evolution reaction. J. Power Sources 2016, 310, 41–46. [Google Scholar] [CrossRef]
- Palanisamy, G.; Bhuvaneswari, K.; Srinivasan, M.; Vignesh, S.; Elavarasan, N.; Venkatesh, G.; Pazhanivel, T.; Ramasamy, P. Two-dimensional g-C3N4 nanosheets supporting Co3O4-V2O5 nanocomposite for remarkable photodegradation of mixed organic dyes based on a dual Z-scheme photocatalytic system. Diam. Relat. Mater. 2021, 118, 108540. [Google Scholar] [CrossRef]
- Janani, B.; Syed, A.; Al-Shwaiman, H.A.; Alkhulaifi, M.M.; Elgorban, A.M.; Khan, S.S. Performance analysis of novel Bi6Cr2O15 coupled Co3O4 nano-heterostructure constructed by ultrasonic assisted method: Visible-light driven photocatalyst and antibacterial agent. Colloids Surf. A 2021, 622, 126671. [Google Scholar] [CrossRef]
- Khatoon, R.; Guo, Y.; Attique, S.; Khan, K.; Treen, A.K.; Haq, M.U.; Tang, H.; Chen, H.; Tian, Y.; Nisar, M.; et al. Facile synthesis of α-Fe2O3/Nb2O5 heterostructure for advanced Li-Ion batteries. J. Alloys Compd. 2020, 837, 155294. [Google Scholar] [CrossRef]
- Shen, F.; Sun, Z.; He, Q.; Sun, J.; Kaner, R.B.; Shao, Y. Niobium pentoxide based materials for high rate rechargeable electrochemical energy storage. Mater. Horiz. 2021, 8, 1130–1152. [Google Scholar] [CrossRef]
- Nallapureddy, R.R.; Pallavolu, M.R.; Nallapureddy, J.; Yedluri, A.K.; Joo, S.W. Z-scheme photocatalysis and photoelectrochemical platform with a Co3O4-CuO heterogeneous catalyst for the removal of water pollutants and generation of energy. J. Clean. Prod. 2023, 382, 135302. [Google Scholar] [CrossRef]
- Carvalho, K.T.G.; Nogueira, A.E.; Lopes, O.F.; Byzynski, G.; Ribeiro, C. Synthesis of g-C3N4/Nb2O5 heterostructures and their application in the removal of organic pollutants under visible and ultraviolet irradiation. Ceram. Int. 2017, 43, 3521–3530. [Google Scholar] [CrossRef]
- Hao, J.; Peng, S.; Li, H.; Dang, S.; Qin, T.; Wen, Y.; Huang, J.; Ma, F.; Gao, D.; Li, F.; et al. A low crystallinity oxygen-vacancy-rich Co3O4 cathode for high-performance flexible asymmetric supercapacitors. J. Mater. Chem. A 2018, 6, 16094–16100. [Google Scholar] [CrossRef]
- Shi, X.; Quan, S.; Yang, L.; Liu, C.; Shi, F. Anchoring Co3O4 on BiFeO3: Achieving high photocatalytic reduction in Cr(VI) and low cobalt leaching. J. Mater. Sci. 2019, 54, 12424–12436. [Google Scholar] [CrossRef]
- Prabaharan, D.D.M.; Sadaiyandi, K.; Mahendran, M.; Sagadevan, S. Precipitation method and characterization of cobalt oxide nanoparticles. Appl. Phys. A 2017, 123, 264. [Google Scholar] [CrossRef]
- Makula, P.; Pacia, M.; Macyk, W. How to correctly determine the band gap energy of modified semiconductor photocatalysts based on UV-Vis spectra. J. Phys. Chem. Lett. 2018, 9, 6814–6817. [Google Scholar] [CrossRef] [PubMed]
- Mohan, H.; Sethumathavan, V.; Fujii, M.; Ha, G.; Kim, G.; Lee, H.; Shin, T. PdS Coupled Nb2O5 Superstructure for Photocatalytic Overall Water Splitting. ChemCatChem 2023, 15, e202201212. [Google Scholar] [CrossRef]
- Simon, T.; Carlson, M.T.; Stolarczyk, J.K.; Feldmann, J. Electron transfer rate vs recombination losses in photocatalytic H2 generation on Pt-decorated CdS nanorods. ACS Energy Lett. 2016, 1, 1137–1142. [Google Scholar] [CrossRef]
- He, J.; Hu, Y.; Wang, Z.; Lu, W.; Yang, S.; Wu, G.; Wang, Y.; Wang, S.; Gu, H.; Wang, J. Hydrothermal growth and optical properties of Nb2O5 nanorod arrays. J. Mater. Chem. C 2014, 2, 8185–8190. [Google Scholar] [CrossRef]
- Gendo, K.M.; Feyisa Bogale, R.; Kenasa, G. Green Synthesis, Characterization, and Evaluation of Photocatalytic and Antibacterial Activities of Co3O4-ZnO Nanocomposites Using Calpurnia aurea Leaf Extract. ACS Omega 2024, 9, 28354–28371. [Google Scholar] [CrossRef]
- Tahir, N.; Zahid, M.; Jillani, A.; Yaseen, M.; Abbas, Q.; Abdul shakoor, R.; Shahid, I. Ternary silver tungstate-MoS2/graphene oxide heterostructure nanocomposite for enhanced photocatalysis under visible light and antibacterial activity. J. Photochem. Photobiol. A 2023, 436, 114376. [Google Scholar] [CrossRef]
- Ray, S.K.; Dhakal, D.; Kshetri, Y.K.; Lee, S.W. Cu-α-NiMoO4 photocatalyst for degradation of Methylene blue with pathways and antibacterial performance. J. Photochem. Photobiol. A 2017, 348, 18–32. [Google Scholar] [CrossRef]
- Munawar, T.; Nadeem, M.S.; Mukhtar, F.; Manzoor, S.; Ashiq, N.M.; Batool, S.; Hasan, M.; Iqbal, F. Multifunctional dual Z-scheme heterostructured Sm2O3-WO3-La2O3 nanocomposite: Enhanced electrochemical, photocatalytic, and antibacterial properties. Adv. Powder Technol. 2023, 34, 104061. [Google Scholar] [CrossRef]
- Sapkota, K.P.; Lee, I.; Shrestha, S.; Islam, A.; Hanif, A.; Akter, J.; Hahn, J.R. Coherent CuO-ZnO nanobullets maneuvered for photocatalytic hydrogen generation and degradation of a persistent water pollutant under visible-light illumination. J. Environ. Chem. Eng. 2021, 9, 106497. [Google Scholar] [CrossRef]
- Xu, Y.; Schoonen, M.A.A. The absolute energy positions of conduction and valence bands of selected semiconducting minerals. Am. Mineral. 2000, 85, 543–556. [Google Scholar] [CrossRef]
- Kumar, K.V.; Porkodi, K.; Rocha, F. Langmuir–Hinshelwood kinetics—A theoretical study. Catal. Commun. 2008, 9, 82–84. [Google Scholar] [CrossRef]
- Nassar, M.Y.; Aly, H.M.; Abdelrahman, E.A.; Moustafa, M.E. Synthesis, characterization, and biological activity of some novel schiff bases and their Co(II) and Ni(II) complexes: A new route for Co3O4 and NiO nanoparticles for photocatalytic degradation of methylene blue dye. J. Mol. Struct. 2017, 1143, 462–471. [Google Scholar] [CrossRef]
- Yadav, S.; Yadav, J.; Kumar, M.; Saini, K. Synthesis and characterization of nickel oxide/cobalt oxide nanocomposite for effective degradation of methylene blue and their comparative electrochemical study as electrode material for supercapacitor application. Int. J. Hydrogen Energy 2022, 47, 41684–41697. [Google Scholar] [CrossRef]
- Saranya, J.; Ranjith, K.S.; Saravanan, P.; Mangalaraj, D.; Kumar, R.T.R. Cobalt-doped cerium oxide nanoparticles: Enhanced photocatalytic activity under UV and visible light irradiation. Mater. Sci. Semicond. Process. 2014, 26, 218–224. [Google Scholar] [CrossRef]
- Chinnathambi, A.; Nasif, O.; Alharbi, S.A.; Khan, S.S. Enhanced optoelectronic properties of multifunctional MnFe2O4 nanorods decorated Co3O4 nanoheterostructure: Photocatalytic activity and antibacterial behavior. Mater. Sci. Semicond. Process. 2021, 134, 105992. [Google Scholar] [CrossRef]
- Zarrin, S.; Heshmatpour, F. Photocatalytic activity of TiO2/Nb2O5/PANI and TiO2/Nb2O5/RGO as new nanocomposites for degradation of organic pollutants. J. Hazard. Mater. 2018, 351, 147–159. [Google Scholar] [CrossRef]
- Oliveira, L.C.; Oliveira, H.S.; Mayrink, G.; Mansur, H.S.; Mansur, A.A.; Moreira, R.L. One-pot synthesis of CdS@ Nb2O5 core–shell nanostructures with enhanced photocatalytic activity. Appl. Catal. B 2014, 152, 403–412. [Google Scholar] [CrossRef]
- Moraes, N.P.d.; Silva, M.L.C.P.d.; Rodrigues, L.A. Effect of metal doping in the photocatalytic properties of carbon xerogel-Nb2O5 composite towards visible light degradation of methylene blue. Mater. Lett. 2018, 228, 486–489. [Google Scholar] [CrossRef]
- Danish, M.; Pandey, A. Influence of thickness and calcination under ammonia gas flow on topographical, optical and photocatalytic properties of Nb2O5 thin films prepared by sol–gel: A comparative study. J. Mater. Sci. Mater. Electron. 2016, 27, 6939–6946. [Google Scholar] [CrossRef]
- Ajami, A.; Sheibani, S.; Ataie, A. S-scheme CoFe2O4/g-C3N4 nanocomposite with high photocatalytic activity and antibacterial capability under visible light irradiation. J. Mater. Res. Technol. 2024, 30, 2168–2185. [Google Scholar] [CrossRef]
- Zhou, B.; Zhao, X.; Liu, H.; Qu, J.; Huang, C.P. Visible-light sensitive cobalt-doped BiVO4 (Co-BiVO4) photocatalytic composites for the degradation of methylene blue dye in dilute aqueous solutions. Appl. Catal. B 2010, 99, 214–221. [Google Scholar] [CrossRef]
- Brites-Nóbrega, F.F.; Lacerda, I.A.; Santos, S.V.; Amorim, C.C.; Santana, V.S.; Fernandes-Machado, N.R.; Ardisson, J.D.; Henriques, A.B.; Leão, M.M. Synthesis and characterization of new NaX zeolite-supported Nb, Zn, and Fe photocatalysts activated by visible radiation for application in wastewater treatment. Catal. Today 2015, 240, 168–175. [Google Scholar] [CrossRef]
- Mobeen, A.A.; Jasmine, S.S.K.; Sundaram, R.; Maria, M.C.; Kaviyarasu, K.; Letsholathebe, D.; Mohamed, S.B.; Kennedy, J.; Maaza, M. Antibacterial, magnetic, optical and humidity sensor studies of beta-CoMoO4–Co3O4 nanocomposites and its synthesis and characterization. J. Photochem. Photobiol. B 2018, 183, 233–241. [Google Scholar] [CrossRef]

| Samples | S. aureus (mm) | E. coli (mm) |
|---|---|---|
| CONP | 5.8 | 4.0 |
| CNNC-1 (1:1) | 6.2 | 4.8 |
| CNNC-2 (1:2) | 7.8 | 4.9 |
| CNNC-3 (2:1) | 9.3 | 6.8 |
| NONP | 0 | 0 |
Disclaimer/Publisher’s Note: The statements, opinions and data contained in all publications are solely those of the individual author(s) and contributor(s) and not of MDPI and/or the editor(s). MDPI and/or the editor(s) disclaim responsibility for any injury to people or property resulting from any ideas, methods, instructions or products referred to in the content. |
© 2025 by the authors. Licensee MDPI, Basel, Switzerland. This article is an open access article distributed under the terms and conditions of the Creative Commons Attribution (CC BY) license (https://creativecommons.org/licenses/by/4.0/).
Share and Cite
Pandey, A.; Shrestha, S.; Kandel, R.; Gyawali, N.; Acharya, S.; Nepal, P.; Gaire, B.; Fualo, V.; Hahn, J.R. Visible-Light-Driven Co3O4/Nb2O5 Heterojunction Nanocomposites for Efficient Photocatalytic and Antimicrobial Performance in Wastewater Treatment. Molecules 2025, 30, 2561. https://doi.org/10.3390/molecules30122561
Pandey A, Shrestha S, Kandel R, Gyawali N, Acharya S, Nepal P, Gaire B, Fualo V, Hahn JR. Visible-Light-Driven Co3O4/Nb2O5 Heterojunction Nanocomposites for Efficient Photocatalytic and Antimicrobial Performance in Wastewater Treatment. Molecules. 2025; 30(12):2561. https://doi.org/10.3390/molecules30122561
Chicago/Turabian StylePandey, Anil, Santu Shrestha, Rupesh Kandel, Narayan Gyawali, Subas Acharya, Pujan Nepal, Binod Gaire, Vince Fualo, and Jae Ryang Hahn. 2025. "Visible-Light-Driven Co3O4/Nb2O5 Heterojunction Nanocomposites for Efficient Photocatalytic and Antimicrobial Performance in Wastewater Treatment" Molecules 30, no. 12: 2561. https://doi.org/10.3390/molecules30122561
APA StylePandey, A., Shrestha, S., Kandel, R., Gyawali, N., Acharya, S., Nepal, P., Gaire, B., Fualo, V., & Hahn, J. R. (2025). Visible-Light-Driven Co3O4/Nb2O5 Heterojunction Nanocomposites for Efficient Photocatalytic and Antimicrobial Performance in Wastewater Treatment. Molecules, 30(12), 2561. https://doi.org/10.3390/molecules30122561

